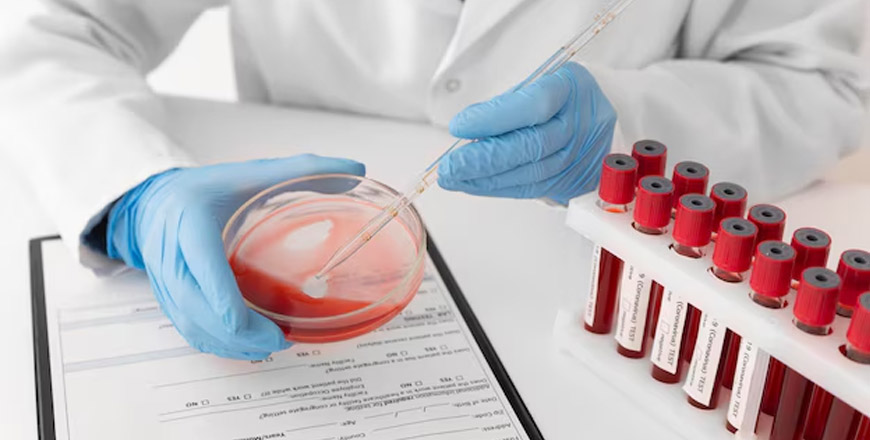

Área Hematología
El hemograma y las pruebas de coagulación. Son estudios sencillos pero que aportan una gran cantidad de información sobre el estado de salud de las personas. En el hemograma se estudian los hematíes o glóbulos rojos, leucocitos y plaquetas, analiza sus proporciones relativas, el estado general de las células y las enfermedades provocadas por los desequilibrios de ellas. En lo que corresponde a las pruebas de coagulación sanguínea, éstas se solicitan como parte de las exploraciones preoperatorias antes de una intervención quirúrgica o para el control del tratamiento anticoagulante.
Exámenes
- Hemograma / VHS
- Hematocrito
- Hemoglobina
- Recuento de plaquetas
- Recuento de reticulocitos
- Tiempo de protrombina
- TTPK
- Tiempo de sangría de Ivy
- Grupo sanguíneo / RH
- Recuento de eosinófilos nasales
PREGUNTAS FRECUENTES
¿Qué son los exámenes de hematología y para qué sirven?
Los exámenes de hematología analizan las células de la sangre, como glóbulos rojos, glóbulos blancos y plaquetas. Se realizan para diagnosticar anemias, infecciones, trastornos de coagulación y enfermedades como leucemias o linfomas.
¿Qué incluye un examen de hematología?
Incluye pruebas como el hemograma completo, tiempo de coagulación, conteo de plaquetas y análisis de glóbulos blancos y rojos. Dependiendo de tus síntomas, el médico puede solicitar pruebas más específicas.
¿Cómo debo prepararme para un examen de hematología?
Por lo general, no se requiere preparación especial, pero si tu médico solicita pruebas específicas como niveles de hierro o vitamina B12, podría ser necesario ayuno de 8 a 12 horas. Siempre consulta con el laboratorio para confirmar los requisitos.
¿Cómo se realiza el examen de hematología?
Se extrae una muestra de sangre de una vena del brazo. Es un procedimiento sencillo y rápido que suele durar solo unos minutos.
¿Cuánto tiempo tardan los resultados de los exámenes de hematología?
Los resultados de pruebas básicas como el hemograma completo suelen estar disponibles el mismo día o en 24 horas. Pruebas más específicas pueden tardar algunos días.
¿Qué pasa si los resultados muestran valores anormales?
Los valores anormales pueden indicar problemas como anemia, infecciones o trastornos de coagulación. El médico interpretará los resultados en función de tu historial médico y síntomas, y podría solicitar pruebas adicionales para confirmar un diagnóstico.
55 2 686244
